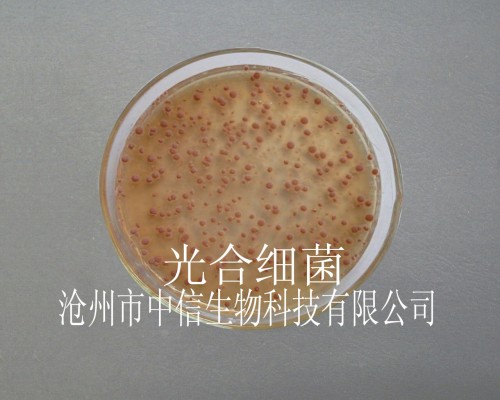
供应光合细菌

光合菌

光合细菌
图片尺寸1036x684
水产养殖:自培优质光合菌的培养步骤及注意事项,低成本用菌惊喜
图片尺寸640x650
光合菌在水产养殖中的作用和使用时间,光合菌与芽孢
图片尺寸800x320
最适合用于水产调水的菌株有哪些?
图片尺寸640x452
鱼得意光合菌(粉剂)不满意产品效果,首单全额退款 总菌数大于 - 抖音
图片尺寸1920x1690
水产养殖中不同有益菌有不同作用菌类到底怎么用
图片尺寸650x426
紫色细菌或成环保小能手分解污水造可再生清洁能源
图片尺寸1080x714
光合细菌水产养殖调水净水抑制有害藻类鱼虾蟹塘分解有机质光合菌
图片尺寸800x800
供应光合细菌
图片尺寸500x400
提到水产养殖中光合菌的应用,水产朋友们可以说非常了
图片尺寸640x445
厂家供应饲料原料净化水质,培养有益藻类和天热饵料【光合细菌】
图片尺寸570x569
农派活性光合菌剂-农用活性微生物菌剂主要技术指标
图片尺寸2032x2471
光合菌一亩用量多少
图片尺寸640x480
90%的妈妈做错了这两点!
图片尺寸351x221
水产养殖:自培优质光合菌的培养步骤及注意事项,低成本用菌惊喜
图片尺寸640x853
水产五种有益菌种:光合菌,芽孢杆菌,乳酸杆菌,硝化菌和酵母菌
图片尺寸998x748
光合细菌培养基 新配方 不发黑不粘壁不分层 培养时间短
图片尺寸1920x1440
动物益生菌的功效与作用 动物益生菌的功效与作用及副作用
图片尺寸500x294
光合细菌 净化水质 作为鱼苗的开口饵料
图片尺寸1024x1024
光合细菌 珺兴实业畜禽水产饲料添加净化水质培养有益藻类
图片尺寸750x750